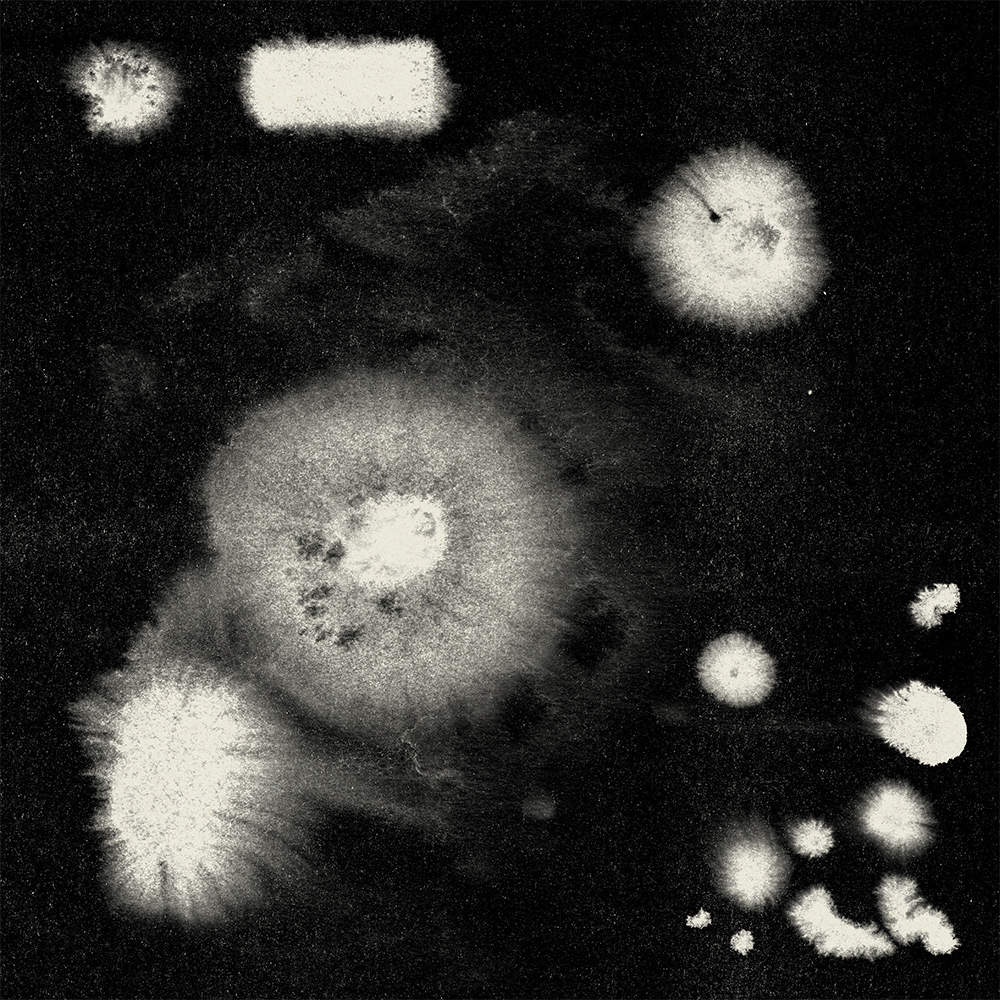

Title: ele - daze - album & EP artwork
Client: ele
Date: 2024
Client: ele
Date: 2024
I had the pleasure of creating the artwork for ele’s solo album elements + daze EP.
The concept originated from ele’s interest in the scientific idea of “deep time” (Tiefenzeit), which inspired me to explore visual layering through ink marbling, also known as suminagashi.
The concept originated from ele’s interest in the scientific idea of “deep time” (Tiefenzeit), which inspired me to explore visual layering through ink marbling, also known as suminagashi.